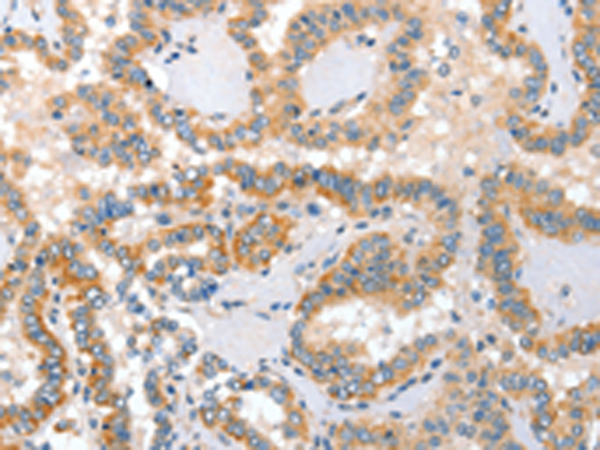
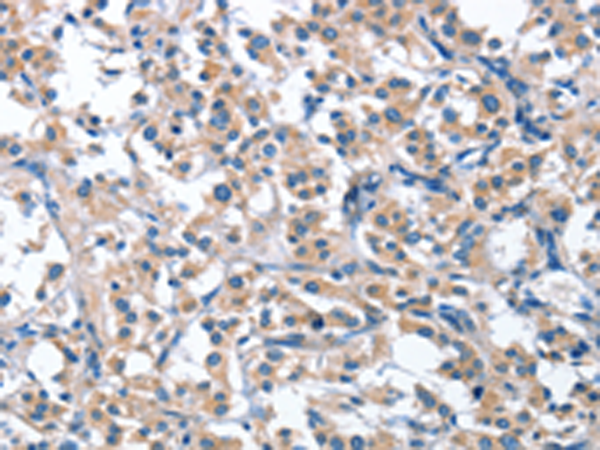
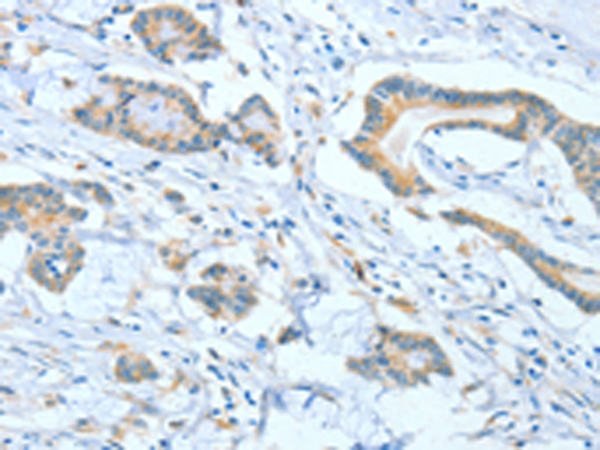
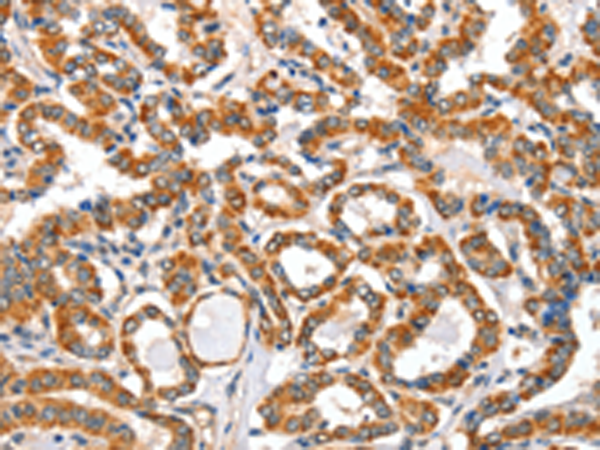
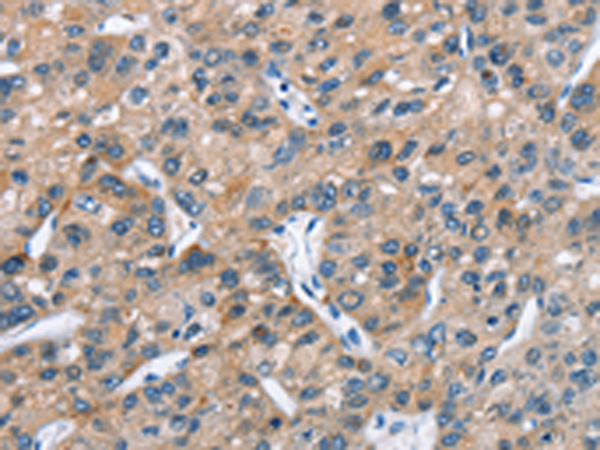
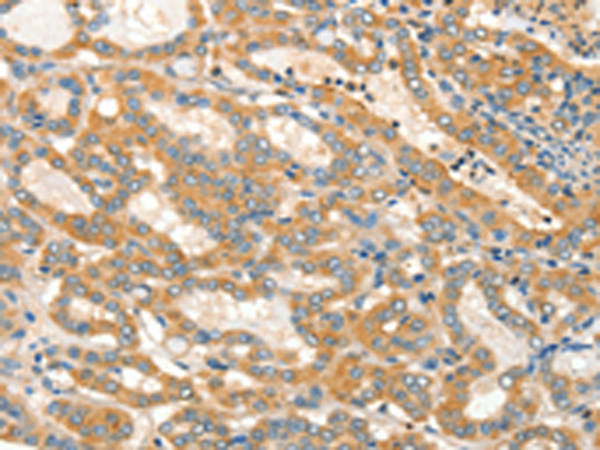

-
分类: 科研抗体货号: P08029别名: ASB-4应用: IHC反应种属: Human, Mouse
-
分类: 科研抗体货号: P08044别名: ALP; PALP; PLAP; PLAP-1应用: WB,IHC反应种属: Human
-
分类: 科研抗体货号: P08033别名: ASH2; Bre2; ASH2L1; ASH2L2应用: IHC反应种属: Human, Mouse
-
分类: 科研抗体货号: P08043别名: AIO; AIOLOS; ZNFN1A3应用: IHC反应种属: Human, Mouse
-
分类: 科研抗体货号: P08049别名: ASB-2应用: IHC反应种属: Human, Mouse, Rat
-
分类: 科研抗体货号: P08031别名: p50; CGI-18; ASC1p50应用: IHC反应种属: Human, Mouse
-
分类: 科研抗体货号: P08042别名: AIFL应用: WB,IHC反应种属: Human, Mouse
-
分类: 科研抗体货号: P08048别名: ALEX2应用: IHC反应种属: Human, Mouse
-
分类: 科研抗体货号: P08059别名: AXIL; ODCRCS应用: WB,IHC反应种属: Human, Mouse, Rat
-
分类: 科研抗体货号: P08040别名: AC3应用: IHC反应种属: Human, Mouse, Rat

鄂公网安备42018502007531号
鄂公网安备42018502007531号

